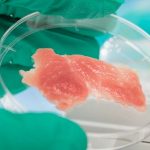
Carne producida por cultivo de células

El siguiente proyecto posiblemente le suene a broma o quizá locura a más de un lector, acabamos de conocer una campaña puesta en marcha en la plataforma de crowdfunding o micromecenazgo IndieGoGo, que tiene como finalidad recaudar un millón de dólares (801.000 euros) para poder abrir un restaurante McDonald’s en una iglesia, se trata del proyecto McMass.
Como decíamos, suena a broma pero no es así, uno de los tres responsables del proyecto asegura que se trata de una idea que tiene como cometido captar a la gente joven para que acudan a la iglesia. Explica que actualmente el cristianismo no es capaz de captar la atención del público, de hecho, el cristianismo ha crecido en Estados Unidos durante la última década sólo un 4% y sólo en algunos Estados. Los estadounidenses cada vez son más reacios a la religión y en raras ocasiones asisten a los servicios religiosos. Con el propósito de buscar fórmulas para captar nuevos feligreses, han optado por intentar abrir una franquicia de McDonald’s en una iglesia.
Creen que McMass puede ayudar porque renovaría la imagen de la iglesia, brindando un servicio que agrada mucho a los estadounidenses, la comida rápida. A los responsables del proyecto les preocupa ver como las iglesias se quedan sin feligreses, cada año 3 millones de personas abandonan la iglesia, a este ritmo muchas se verán obligadas a cerrar sus puertas.
Los creadores del Proyecto McMass para abrir un McDonald’s en una iglesia, explican que estos espacios se enfrentan a varios problemas, apoyo financiero, captar la atención del público, reafirmar su posición como centro de reunión, etc. Para resolver este problema es necesario que las iglesias se comprometan y lleven a cabo una actividad empresarial, abrir un restaurante de comida rápida de la franquicia ayudaría a conectar con el mundo moderno y resolver los problemas antes citados. Sería interesante saber en qué se basan para asegurar que esa es la solución, y más sabiendo que hay una guerra contra el sobrepeso y la obesidad.
¿Qué ofrece un McDonald’s? Es una franquicia muy rentable, es una marca icónica que puede captar la atención de muchas personas y daría un valor añadido a las iglesias. ¿Para qué quieren tanto dinero? Para poder poner en marcha el restaurante, pagar la correspondiente franquicia, destinar parte de los fondos a la construcción del restaurante, así como a las reformas y cambios en la infraestructura del interior y exterior de la iglesia.
Curiosamente han puesto en marcha el proyecto y ni siquiera cuentan con una iglesia que se preste a este cambio, están buscando una en Nueva Jersey o el área de Filadelfia. A esto hay que añadir que según comentan en NBC News, se ha intentado contactar con un representante de la cadena de comida rápida para que explicara algunos detalles del proyecto en el caso de que estén de acuerdo con la iniciativa, algo que no ha sido posible.
Los responsables del Proyecto McMass creen que si logran reunir el dinero, estarán en plenas condiciones de presentar un plan de trabajo para iniciar la implementación. Se trata de una nueva y audaz visión de cómo las iglesias pueden participar con sus comunidades, aumentar en número de feligreses y prosperar. Con las donaciones se promete ofrecer pegatinas con un logo creado a partir de la fusión de la iglesia y McDonald’s, camisetas y gorras.
Los responsables del proyecto esperan que el público se una a ellos en esta iniciativa que pretende revitalizar las iglesias del mundo moderno, creen que el espíritu empresarial es la clave para la buena marcha de las iglesias, asegurando que podrían garantizar que las comunidades eclesiásticas no sólo sobrevivan, sino que también puedan crecer y prosperar.
Parece evidente que McMass es un proyecto abocado al fracaso, la campaña en IndieGoGo se puso en marcha el pasado 17 de noviembre y de momento han logrado recaudar 77 dólares. Considerar que un restaurante McDonald’s sería la salvación de la iglesia es una idea totalmente disparatada.